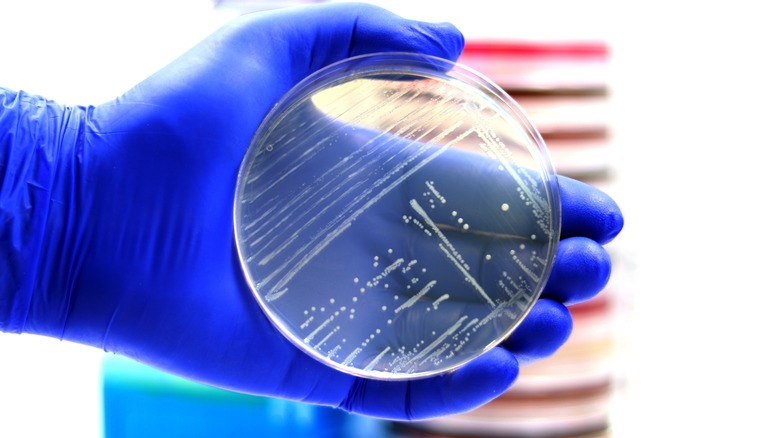

6 Major Grocery Chains Affected By Nationwide Frozen Fruit Recall
If you have purchased frozen fruit in the last several months, you may want to look closely at the package information because there is a major recall due to the possible presence of listeria. Sunrise Growers, Inc. issued the voluntary recall and announced that the potential bacteria is linked to pineapple from a third-party supplier. It may affect several different brands and types of fruit sold at Walmart, Whole Foods, Trader Joe's, Target, Aldi, and AWG (Associated Wholesale Grocers).
The U.S. Food and Drug Administration (FDA) shared the extensive list of products and brands on its website, along with lot codes, distribution dates, and contact information for Sunrise Growers. The products range from bags of mixed fruit containing pineapple to other solitary fruits that may have had contact with the pineapple in question like frozen cherries and mango chunks. Those who have purchased any of the fruit listed are urged to discard the bags completely or return them for a refund.
Why is the fruit dangerous?
While there haven't been any reported illnesses associated with this recall to date, keeping and consuming the questionable fruit is not a risk worth taking for anybody. According to the Centers for Disease Control and Prevention (CDC), Listeria monocytogenes kills around 260 people every year and infects about 1,600. It's particularly dangerous for small children, the elderly, those who are pregnant, and anyone with a weakened immune system. Even healthy individuals can suffer from symptoms such as high fever, headache, stiffness, nausea, stomach pain, and diarrhea if exposed to the bacteria.
The recalled products have distribution dates ranging from October 11, 2022 to June 21, 2023 and affect some very popular brands like Great Value, 365 Organic, Good & Gather, and Season's Choice. Retailers who sell these brands and any others that have been affected should have been notified of the recall and removed the products from shelves immediately, so any frozen fruit you purchase going forward should have been checked and cleared for sale.